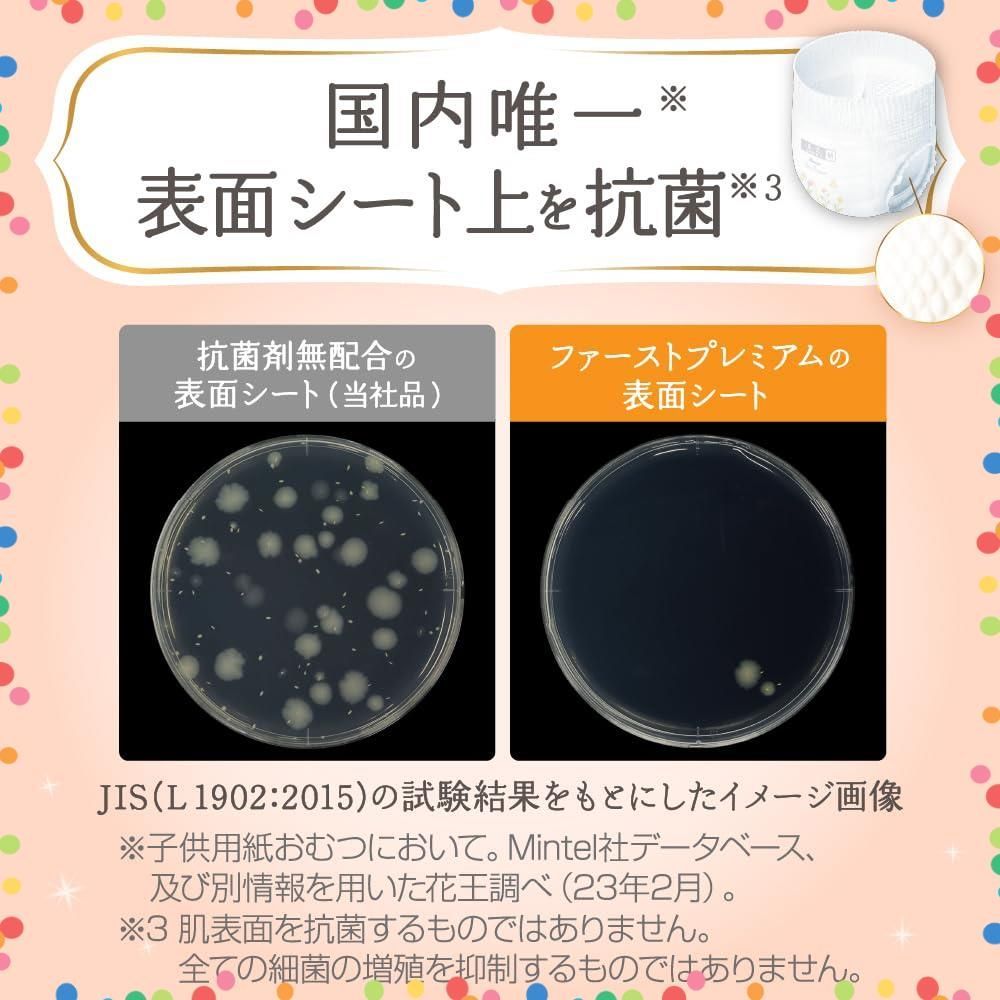

- www.aprilflower.org
- パーツレビュー
- タイヤ・ホイール
- タイヤ
- キッチン・日用品・その他
- 文房具・事務用品
- {{prodcut_title}}
商品 ファースト 12 22 kg ケース品 繊細な肌に5ッ星のやさしさを ビッグサイズ メリーズ パンツ
商品 ファースト 12 22 kg ケース品 繊細な肌に5ッ星のやさしさを ビッグサイズ メリーズ パンツ
4.4点
(355件)
レビュー一覧 355件 (総件数:355件)
おすすめの商品
Yahoo!ショッピングの商品を見る
[PR]
ご覧いただきありがとうございます。
当店では他サイトにも商品を販売しているため
まれに売り切れや取り寄せ中となる場合がありますがご了承ください。
【パンツ ビッグサイズ】メリーズ ファーストプレミアム(12~22kg)128枚(32枚×4パック) [ケース品]「繊細な肌に5ッ星のやさしさを」
「繊細な肌に5ッ星のやさしさを」
おむつ内環境を清潔に保ち、健やかな肌へ
[ケース品] 128枚(32枚×4パック)
繊細な肌に5ツ星のやさしさを* 2倍やわらか※1カシミヤタッチ 繊細なお肌をやさしく包みこむ上質な肌触り 2.5倍※のびーる ふんわり快適ソフトフィット どんな動きにもしなやかにフィット 赤ちゃん快適&モレ安心 ※伸ばす前に対して(花王調べ) ゆるうんち吸収 凹凸シート 独自の凹凸シートで肌あたりやわらかうんちも肌につきにくい 天然植物成分アルガンオイル配合 肌に触れる表面シートにオーガニック高純度オイル配合 表面シート上を抗菌※2 肌に触れる表面シート上で菌の増殖を抑制 アレルギーテスト済み※3 絵本の世界をモチーフにした上質なデザイン *メリーズ内において ※1 外装部分当社品比 ※2 肌表面を抗菌するものではありません。すべての細菌の増殖を抑制するものではありません。 ※3 表面シートにおける試験・すべての方にアレルギーが起こらないというわけではありません。 お肌いつもさらさら 100%通気素材 朝まで安心 長時間吸収 交換時が一目でわかる おしっこサイン 伸びてピタッと! まとまるテープ
原材料・成分
素材 表面材 ポリエステル/ポリオレフィン不織布 吸水材 吸収紙/綿状パルプ/アクリル系高分子吸水材 防水材 ポリオレフィン系フィルム 止着材 ポリオレフィン系フィルム 伸縮材 ポリウレタン 結合材 スチレン系エラストマー合成樹脂など
安全警告
使用上の注意 ご使用前に必ずお読みください ●こまめに交換し、肌に残ったうんちはきれいに拭き取ってください。 ●お肌に異常が出たら使用を中止し、医師にご相談ください。 ●お子様が紙おむつや外袋を口に入れないよう、手の届かない所に保管してください。 ●おしっこお知らせサインは、未使用でも湿度の高い条件で、部分的に色が変わることがありますが、ご使用には問題ありません。また、日光や温度など環境の影響で、吸収後のサインの色が緑がかった青になることもあります。 ●変形・変色のおそれがありますので、暖房器具の近くなど高温になる所に置かないでください。 ●外袋の色が落ちることがありますので、洗剤などが付着しないようご注意ください。 ●メリーズに使用されている高分子吸水材は、水分を吸収するとゼリー状の粒になります。お子様の肌に触れても安全です。 ●誤って洗濯した時は、脱水後、衣類についたパルプやゼリー状の粒をはたき落とし、洗濯機内部に残ったものは取り除いてください。 使用上の注意 *汚れた紙おむつは早くとりかえてください。 *テープは直接お肌につけないでください。 *誤って口に入れたり、のどにつまらせることのないよう保管場所に注意し、使用後はすぐに処理してください。 保管上の注意 *開封後は、ほこりや虫が入らないよう、衛生的に保管してください。
最後までご確認頂き誠にありがとうございました。
上記をご確認頂き、ご購入いただけましたら幸いです。
何かご不明な点がございましたらお気軽にメッセージからお問い合わせ下さい。
当店では他サイトにも商品を販売しているため
まれに売り切れや取り寄せ中となる場合がありますがご了承ください。
【パンツ ビッグサイズ】メリーズ ファーストプレミアム(12~22kg)128枚(32枚×4パック) [ケース品]「繊細な肌に5ッ星のやさしさを」
「繊細な肌に5ッ星のやさしさを」
おむつ内環境を清潔に保ち、健やかな肌へ
[ケース品] 128枚(32枚×4パック)
繊細な肌に5ツ星のやさしさを* 2倍やわらか※1カシミヤタッチ 繊細なお肌をやさしく包みこむ上質な肌触り 2.5倍※のびーる ふんわり快適ソフトフィット どんな動きにもしなやかにフィット 赤ちゃん快適&モレ安心 ※伸ばす前に対して(花王調べ) ゆるうんち吸収 凹凸シート 独自の凹凸シートで肌あたりやわらかうんちも肌につきにくい 天然植物成分アルガンオイル配合 肌に触れる表面シートにオーガニック高純度オイル配合 表面シート上を抗菌※2 肌に触れる表面シート上で菌の増殖を抑制 アレルギーテスト済み※3 絵本の世界をモチーフにした上質なデザイン *メリーズ内において ※1 外装部分当社品比 ※2 肌表面を抗菌するものではありません。すべての細菌の増殖を抑制するものではありません。 ※3 表面シートにおける試験・すべての方にアレルギーが起こらないというわけではありません。 お肌いつもさらさら 100%通気素材 朝まで安心 長時間吸収 交換時が一目でわかる おしっこサイン 伸びてピタッと! まとまるテープ
原材料・成分
素材 表面材 ポリエステル/ポリオレフィン不織布 吸水材 吸収紙/綿状パルプ/アクリル系高分子吸水材 防水材 ポリオレフィン系フィルム 止着材 ポリオレフィン系フィルム 伸縮材 ポリウレタン 結合材 スチレン系エラストマー合成樹脂など
安全警告
使用上の注意 ご使用前に必ずお読みください ●こまめに交換し、肌に残ったうんちはきれいに拭き取ってください。 ●お肌に異常が出たら使用を中止し、医師にご相談ください。 ●お子様が紙おむつや外袋を口に入れないよう、手の届かない所に保管してください。 ●おしっこお知らせサインは、未使用でも湿度の高い条件で、部分的に色が変わることがありますが、ご使用には問題ありません。また、日光や温度など環境の影響で、吸収後のサインの色が緑がかった青になることもあります。 ●変形・変色のおそれがありますので、暖房器具の近くなど高温になる所に置かないでください。 ●外袋の色が落ちることがありますので、洗剤などが付着しないようご注意ください。 ●メリーズに使用されている高分子吸水材は、水分を吸収するとゼリー状の粒になります。お子様の肌に触れても安全です。 ●誤って洗濯した時は、脱水後、衣類についたパルプやゼリー状の粒をはたき落とし、洗濯機内部に残ったものは取り除いてください。 使用上の注意 *汚れた紙おむつは早くとりかえてください。 *テープは直接お肌につけないでください。 *誤って口に入れたり、のどにつまらせることのないよう保管場所に注意し、使用後はすぐに処理してください。 保管上の注意 *開封後は、ほこりや虫が入らないよう、衛生的に保管してください。
最後までご確認頂き誠にありがとうございました。
上記をご確認頂き、ご購入いただけましたら幸いです。
何かご不明な点がございましたらお気軽にメッセージからお問い合わせ下さい。
カテゴリー:
キッチン・日用品・その他##文房具・事務用品##その他
商品の状態:
新品、未使用
配送料の負担:
送料無料
配送の方法:
未定(出品者が手配)
発送元の地域:
大阪府
発送までの日数:
2~5日